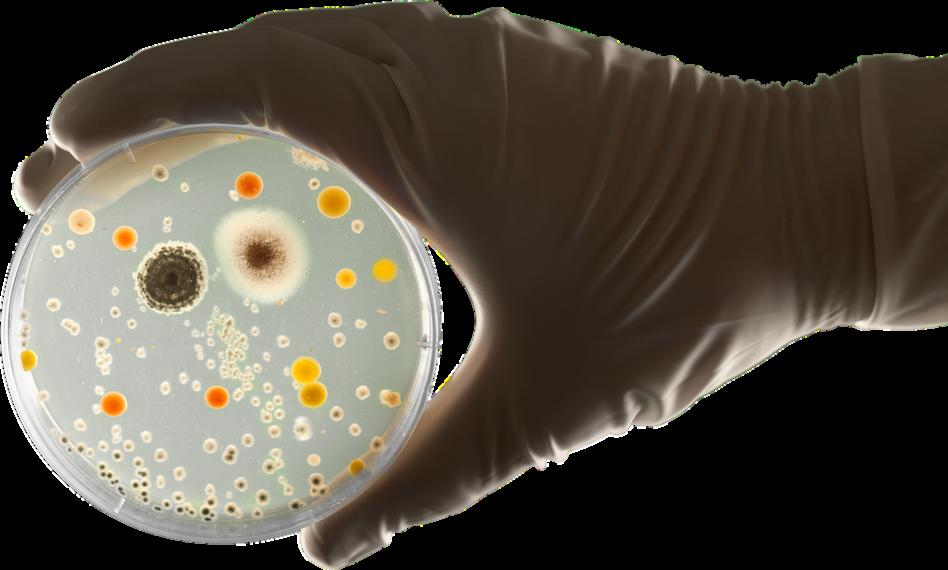

BC Children's Hospital Research Institute receives an annual grant from BC Children's Hospital Foundation.



BC Children's Hospital Research Institute receives an annual grant from BC Children's Hospital Foundation.
The BC Children's Hospital Research Institute (BCCHR) community has more than 1,500 members including 446 investigators, counting affiliate and investigator emeriti, who support more than 400 postdoctoral fellows, doctoral and master's degree students

1,500+ BCCHR research community members

BCCHR investigators' Canadian Institutes of Health Research (CIHR) 2022 Spring Project Grant success rate was 28 per cent, as compared to the national average of 22 per cent.

BCCHR investigators' CIHR 2022 Fall Project Grant success rate was 42 per cent, as compared to the national average of 35 per cent.
1,478 academic publications produced by our investigators in 2022

Our researchers currently hold:
2 distinguished scholar/leadership awards
3 national chairs in science and research
4 national investigator, scholar and clinicianscientist awards

6 young investigator/early career awards



15 Canada Research Chairs
20 Michael Smith Health Research BC scholar and health professional investigator awards


The COVID-19 pandemic has had unprecedented impacts on mental health and access to supports, particularly for those in late adolescence and early adulthood. Dr. Evelyn Stewart, Dr. Hasina Samji and their teams found factors that influenced mental health outcomes included poverty, limited education, gender, LGBTQ2S+ status and previous mental health difficulties

They also found that negative psychiatric impacts of COVID-19, which include poor access to mental health support, clearly persisted beyond the first wave, widening pre-existing inequity gaps
The researchers authored a report that details a list of recommendations to bridge these gaps
"We have recommended that government and health leaders better serve children, youth and young adults in greatest need of mental health support and intervention, and that they enhance social and emotional learning strategies in schools."
Dr. Stewart



Video games can cause life-threatening irregular heart rhythms in susceptible children, according to an international study co-authored by Dr. Shubhayan Sanatani. The researchers uncovered an uncommon, but distinct pattern among children who lose consciousness while playing video games in a study that's believed to be the first research into this subject Of the 22 kids profiled in the study, four of them died Multiplayer war games were the most frequent triggers

There are no underlying heart health risks to playing video games for most kids, but for some children with inherited heart rhythm disorders, or arrhythmias, the findings emphasize the need for enhanced safety plans if they are gaming

"While we know competitive sports and certain high-risk activities can be higher risk for kids with these heart rhythm disorders, electronic gaming is new territory for us when it comes to medical advice provided to these families."
 Dr. Sanatani
Dr. Sanatani
Click to watch Dr. Sanatani speak about the findings.

Providing free-of-charge, after-school bhangra dance classes to South Asian kids improved their aerobic capacity, muscle strength and power, and decreased their waist circumference These were the findings from the first study of its kind that was led by Dr. Tricia Tang and included Dr. Shazhan Amed. Most of the 127 Grades 3 to 6 students who participated in Project Bhangra's biweekly classes over seven months stuck to the program until the end.
"The risk of South Asian children developing heart disease at an early age has both genetic and epigenetic or environmental causes," explains Dr. Tang. "Adopting healthy habits at a young age can provide significant benefits over a lifetime."
"This study shows that culturally based dances, such as bhangra, can promote fitness in children and should be explored in public health interventions," says Dr Amed



An antihistamine commonly prescribed for young children has been associated with a higher risk of tics, anxiety and conduct disorders in a first-of-itskind study led by researcher and director of the Pharmaceutical Outcomes Programme at BC Children's Hospital Dr. Bruce Carleton.

Repeated use of the first-generation antihistamine hydroxyzine in young children, especially those with five or more prescriptions before the age of five, was associated with a higher risk for specific psychomotor disorders such as tics, and a higher risk for anxiety and conduct disorders throughout childhood Hydroxyzine is commonly prescribed for infants and young children with skin conditions such as atopic dermatitis and eczema, allergyrelated nasal congestion, anxiety and nausea
"We now recommend using second-generation antihistamines, topical antihistamines or corticosteroids for preschool-age children If hydroxyzine is required, we suggest the shortest possible duration "
 Dr. Carleton
Dr. Carleton

Ebrahim Aldalati is the first person in the world to be identified as completely deficient in a protein involved in the immune system and cartilage growth. The diagnosis explains why Ebrahim has experienced health issues since he was a toddler that include severe muscle and tendon problems that limit his mobility, numerous colds and infections, and two occurrences of cancer
Researcher and Canada Research Chair in Pediatric Precision Health Dr. Stuart Turvey and Dr. Mehul Sharma, a PhD student in Dr Turvey's lab at the time, diagnosed Ebrahim through the Rare Disease Discovery Hub at BC Children's They completed genetic, blood and tissue testing and carried out a new process that restored the missing protein and reversed damage at the cellular level This finding represents a new and exciting application of precision health, according to Dr Turvey

"Precision health really means applying powerful new technologies to allow us to understand specific genes and proteins that make up a child's body, and we can then pinpoint the molecular causes of disease. We won't just say someone has asthma or joint issues. Now we can drill down to the molecules," he says. "That opens doors to new treatments and new ways to understand biology."

 Dr. Mehul Sharma
Dr. Mehul Sharma

For decades, treating pediatric cancer has been a one-size-fits-all approach. The treatment one child receives for a particular cancer is generally the same that all patients with the same cancer receive, but no two cancers are the same.
Through the Better Responses through Avatars and Evidence (BRAvE) Initiative, researchers with the Michael Cuccione Childhood Cancer Research Program Dr. Philipp Lange, Dr. James Lim, Dr. Christopher Maxwell and Dr. Gregor Reid use cutting-edge technologies to find the individual vulnerabilities of each child's cancer and then grow an avatar model of the child's tumour in the lab The avatar allows researchers to understand how the tumour might grow and respond to medications This work allows them to prepare the best way to treat the child's cancer should it return or prove difficult to treat with conventional therapies.

"In partnership with national initiatives, BRAvE is leading the way toward a new precision medicine approach that begins the moment the child enters the hospital. Right from the child's initial diagnosis, we'll work to develop a personal treatment 'recipe' based on the unique qualities of their cancer cells," says Dr. Lange.

"Our goal is to be ready with the most effective treatment possible for each patient one that we have already thoroughly tested on their specific tumour cells We may not need to use the treatment, but we'll have it ready just in case," says Dr Lim
After building a strong platform in B C , the BRAvE team will continue to provide leadership to national initiatives and work with international partners to help make precision oncology accessible to children everywhere
Researchers at BC Children's want to find a new way to treat diabetes, and potentially prevent it from occurring.
Type 1 diabetes, or T1D, is an autoimmune disease that prevents the pancreas from making insulin, a hormone that regulates the amount of sugar in one's blood Without insulin, blood sugar levels can spike, leading to serious health problems or even death, if not treated

Dr. Bruce Verchere, Dr. Megan Levings and Dr. Ramon Klein Geltink are examining why the immune system attacks the cells in the pancreas that produce insulin This will be the first study to explore whether what the immune cells "eat" increases damage to the pancreas.
Technology now allows researchers to study metabolites and metabolic pathways at a single-cell level and track interactions more extensively. Exploring metabolic pathways will uncover new insights into how islet cell immunometabolism changes in T1D.
"Essentially, we are trying to understand what goes on at the interface of the immune system and pancreatic islets in T1D. We have assembled a dream team with world-leading experts in their fields to come together and study this new idea."


 Dr. Verchere
Dr. Verchere


